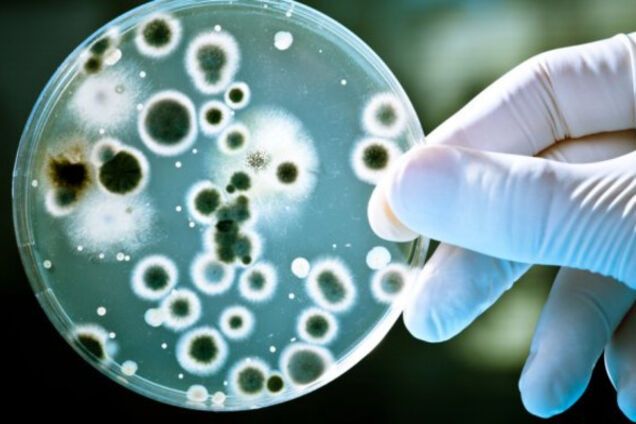
Бактерии

Особо опасны: стало известно, как ведут себя бактерии в космосе
Исследователи из США сообщили, что им удалось доказать опасность бактерий в космосе. Во время эксперимента бактерии, обитавшие на борту МКС, размножались быстрее, чем их представители на Земле.
Эксперименты показали, что в открытом космосе они гораздо активнее размножаются из-за нарушений в транспортировке веществ внутри их клеток. Такой процесс создает эффект "голода" у микроорганизмов.
Кроме того, во время экспериментов было отмечено повышение агрессивности бактерий. В целом, был отмечен целый ряд изменений в их работе.
В настоящий момент ученые намерены также отправить бактерии снаружу космического корабля, чтобы лучше изучить эти процессы при воздействии невесомости и отсутствии атмосферы.










